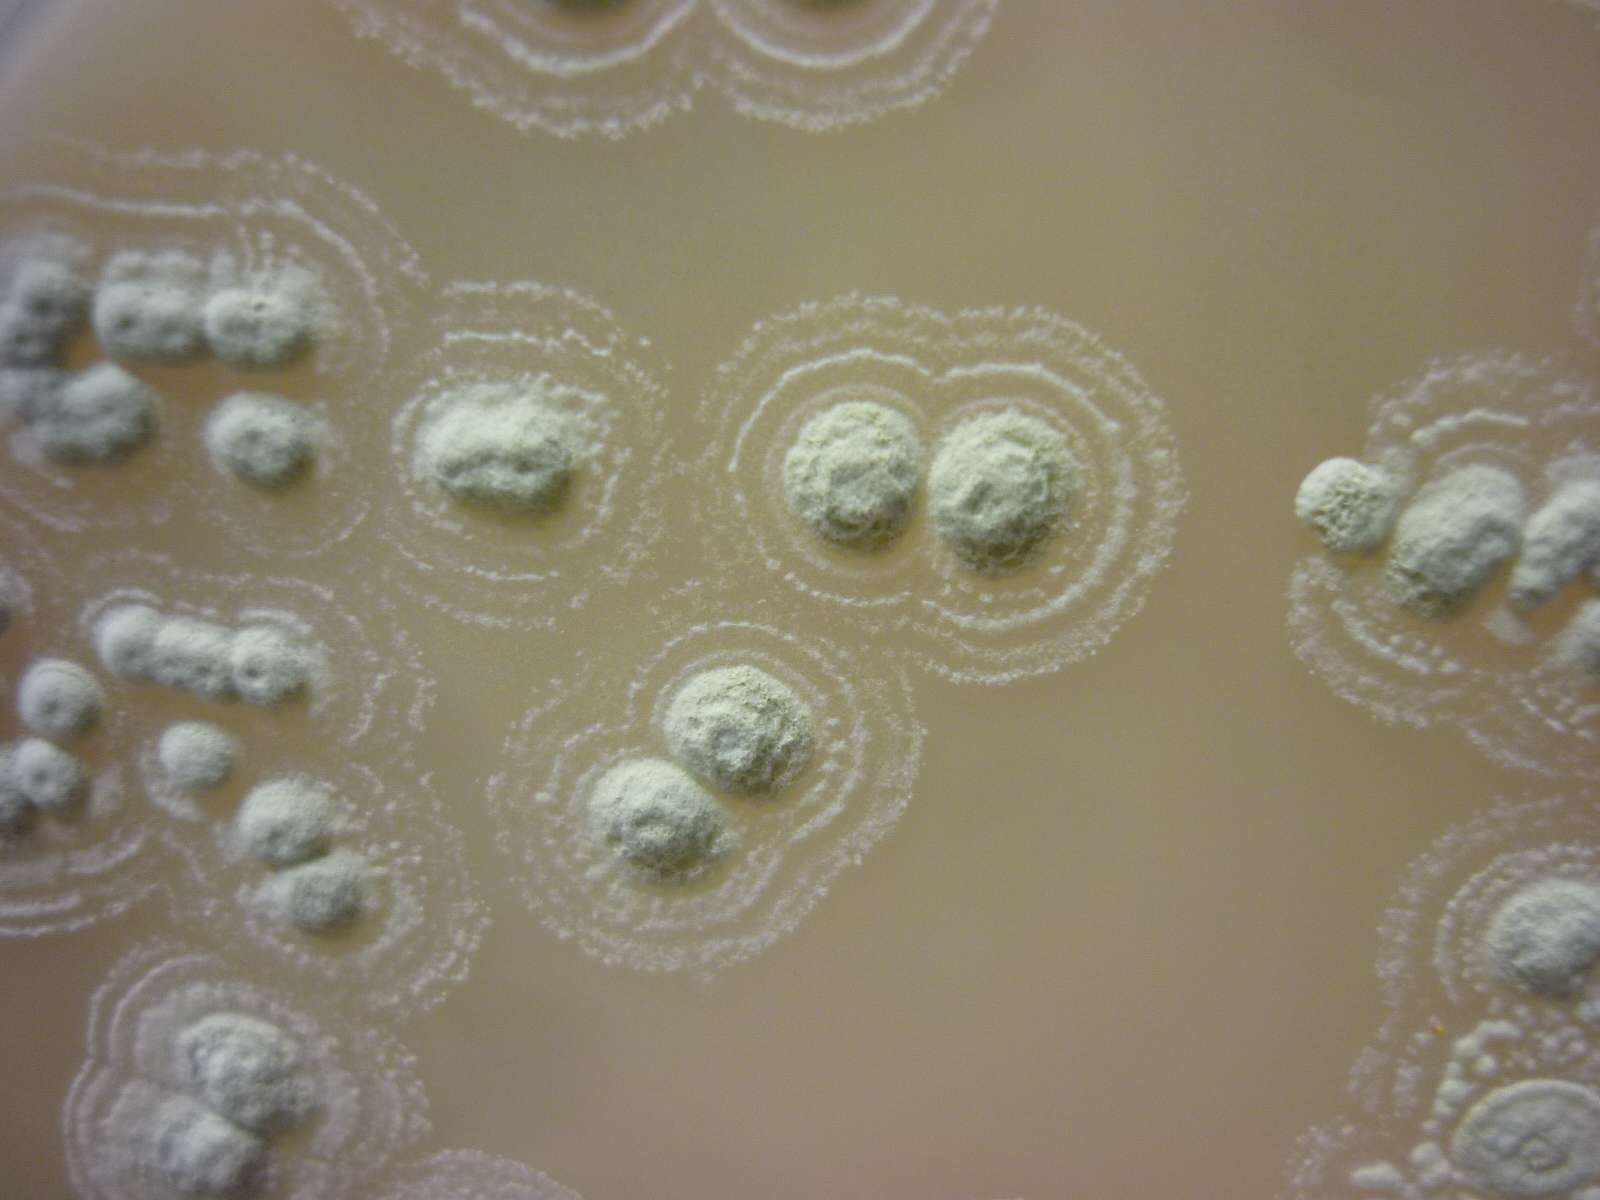

Streptomyces spp что это
Перегородка по системе кнауф с112
Индонезия индонезийская
Духовой шкаф электрический встраиваемый как подключать
Маленький е малышку
Выпиши верные равенства и неравенства 3
Программа рабочих встреч
Puerto rico песня
Фоновый рисунок рабочего стола на весь экран
Завоздушило систему отопления в многоквартирном доме
Труба асбестовая 400 мм
Марксистская политическая экономика
Игры на 1 месте
Институт ухо горло носа и речи
Streptomyces spp что это 114 фото